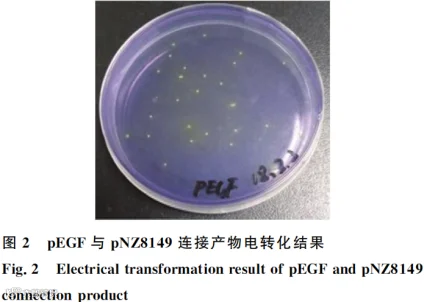
image.png

原文信息:周鑫鑫, 郭莹莹, 肖运才, 王金硕, 周祖涛, 刘华珍, 石德时. 猪表皮生长因子在乳酸乳球菌中的表达及其生物活性研究[J]. 中国畜牧兽医, 2024, 51 (07): 2823-2836.
原文链接:
https://kns.cnki.net/kcms2/article/abstract?v=k15566fjT2mdTZy7Fei7HWCGHAnLRN9IOiqq-IeB8FxucdVEfjR5zxEErlJ6-buQjHHfSY9ISGX9qS42xHCSRVTMGFzAJp6_kmiFivSbAjaRuwNpPjhMSWgGC_hmS9nKE9oL0cZwtiZzGnMozYztyypzCsMSgnFG5Gb01HsYaLY=&uniplatform=NZKPT
本研究目的是构建表达猪表皮生长因子(pEGF)的乳酸乳球菌原核表达系统,并探究其对断奶仔猪腹泻的影响。
利用猪回肠上皮细胞(IPEC-J2)增殖试验体外验证表达的pEGF生物活性。通过动物试验验证重组蛋白pEGF对小鼠及断奶仔猪腹泻的影响。
试验成功构建重组菌pEGF-NZ,并分泌表达pEGF蛋白。体外试验结果显示,pEGF蛋白能促进细胞增殖。pEGF-NZ重组菌及其表达的pEGF蛋白能延缓小鼠腹泻发生时间,降低腹泻率,保护小鼠肠绒毛的完整性。与对照组相比,pEGF-NZ重组菌处理后,小鼠结肠中乳酸菌数显著增加(P<0.05),大肠杆菌数、肠球菌数显著降低(P<0.05),白细胞介素-1α(IL-1α)、IL-1β含量显著降低(P<0.05),IL-13含量显著升高(P<0.05)。
pEGF-NZ重组菌及其分泌表达的pEGF能够修复肠道屏障,抑制病原菌黏附,调控肠道菌群,其主要通过下调部分促炎因子、上调抑炎因子表达发挥抑炎效果,从而保护断奶仔猪肠道健康,有效缓解腹泻。
本研究的主要目的是构建一种能够表达猪表皮生长因子(pEGF)的乳酸乳球菌原核表达系统,并探究其对断奶仔猪腹泻的影响。通过这一研究,我们希望能够找到一种有效的方法来缓解断奶仔猪的腹泻问题,提高其健康状况和生长性能。由于早期断奶会导致仔猪产生应激反应,从而引起腹泻、肠道屏障功能受损等问题,进而影响仔猪的生长速率和生存率。有研究表明,表皮生长因子(EGF)能够促进细胞生长、增殖与分化,参与受损肠道表皮修复,从而减轻腹泻症状。本研究选取无抗筛选标记的乳酸乳球菌表达系统,利用其表达具有修复受损上皮功能的pEGF,将乳酸乳球菌可能的益生作用与 pEGF 的功能相结合,旨在研发一种可保护断奶仔猪肠道健康的制剂,为绿色养猪提供技术支撑。
将200头体况良好且初重为(62.48±0.52)kg的杜×长×大育肥猪随机分为四组,分别饲喂基础日粮加上0 mg/kg(0AP组)、100 mg/kg(100 AP组)、200 mg/kg(200 AP组)和300 mg/kg(300 AP组)的抗菌肽。每组有5个重复,每个重复10头猪。整个试验周期为30天。
实验使用了NZ3900和诱导型表达载体pNZ8149,质粒包含Usp45和His标签,由吉林农业大学动物病毒学实验室馈赠。细菌生长培养基为M17培养基,30℃培养。
重组乳酸乳球菌构建
以实验室前期合成的pUC57-SP45-LEISSTCDA-pEG序列为模板,进行融合PCR扩增,缺失信号肽Usp45与pEGF基因之间的LEISSTCDA序列,然后通过琼脂糖凝胶电泳检测融合PCR产物。将回收片段连接双酶切的载体pNZ8149,利用Transformation Apparatus将质粒电转化至乳酸乳球菌NZ3900,以LacF为筛选标记获得重组菌pEGF-NZ。
使用nisin作为诱导剂,在30℃恒温培养箱中培养乳酸乳球菌NZ3900和pEGF-NZ重组菌,收集上清液进行Western blotting鉴定。将纯化的pEGF蛋白进行Tricine-SDS-PAGE分析鉴定,用BCA试剂盒测定纯化后的蛋白浓度。
pEGF-NZ重组菌发酵条件优化
以 M17 培养基为种子培养基,设置不同条件优化发酵培养基,包括接种量、装液量、碳源、氮源、pH 和温度,进行摇瓶发酵试验,测定菌密度,确定最佳条件。同时采用不同浓度 nisin 诱导重组菌株,确定最佳诱导剂浓度和诱导时间,再进行工业优化。
pEGF蛋白体外生物活性鉴定
通过猪回肠上皮细胞(IPEC-J2)增殖试验检测pEGF-NZ重组菌分泌表达的pEGF蛋白生物活性。设置不同浓度的处理组,观察各处理组细胞生长状态并进行酶标仪检测。
pEGF蛋白在小鼠体内生物活性鉴定
使用鼠伤寒沙门菌感染ICR小鼠建立腹泻模型,分别给小鼠灌胃经nisin诱导20小时的pEGF-NZ重组菌及其培养上清、载体菌液等处理组,观察各组小鼠的生长性能及腹泻情况。
pEGF蛋白在断奶仔猪体内生物活性鉴定
随机分组的断奶仔猪饲喂基础饲粮,每天两次拌料饲喂含有工业生产制粒的pEGF-NZ重组菌和乳酸乳球菌NZ3900发酵颗粒,连续饲喂21天,统计各处理组仔猪的生长性能及腹泻情况。
pEGF-pNZ8149重组乳酸乳球菌构建

融合PCR扩增结果显示,出现单一条带,大小约263 bp(图1),与预期相符。由图2可知,连接产物成功电转化至乳酸乳球菌NZ3900感受态细胞中。菌液PCR鉴定结果显示,条带大小约328 bp(图3),与预期相符。
pEGF蛋白的表达及纯化



Western blotting检测结果显示,pEGF-NZ重组菌成功分泌表达pEGF蛋白,分泌量达1.34 μg/mL,大小约为12 ku(图4)。由图5可知,成功获得纯化的pEGF蛋白。蛋白凝胶质谱定性检测结果显示,该纯化蛋白属于角蛋白14蛋白家族,证明所获蛋白为pEGF蛋白(图6)。
pEGF-NZ重组菌发酵条件优化
1. 装液量和接种量的优化

由图7A可知,20%装液量组pEGF-NZ重组菌的D600 nm值显著高于40%、60%组(P<0.05)。由图7B可知,4%接种量组pEGF-NZ重组菌的D600 nm值显著高于1%、2%、7%组(P<0.05),因此确定最佳装液量为20%、接种量为4%。
2.碳源和氮源的优化

由图8A可知,乳糖为碳源时,pEGF-NZ重组菌的活菌数显著高于葡萄糖、蔗糖和果糖组(P<0.05)。由图8B可知,蛋白胨+酵母粉组pEGF-NZ重组菌的活菌数显著高于蛋白胨、酵母粉、硫酸铵组(P<0.05)。
3.温度和pH的优化

不同温度条件下,pEGF-NZ活菌数无显著差异(P>0.05),但30℃条件下pEGF-NZ活菌数较高(图9A);发酵培养基pH为6.5时pEGF-NZ活菌数显著高于其他组(P<0.05,图9B)。
4.诱导条件的优化


由图10可知,当诱导剂nisin终浓度为5 ng/mL时,pEGF蛋白分泌量最高。由图11可知,随着诱导时间延长,蛋白分泌量逐渐增加,在诱导20 h达到最高,随后下降。
5.工业发酵条件的优化


由图12可知,6 h后pEGF-NZ重组菌进入对数生长期,菌种开始大量增殖,因此选择在菌种发酵至6 h添加诱导剂nisin。由图13可知,工业发酵过程中,以葡萄糖和乳糖为碳源,诱导22 h时蛋白分泌量最高。
pEGF蛋白体外生物活性鉴定


由图14可知,10、20、25、50 ng/mL pEGF-NZ上清处理组中细胞较密,生长状态较好。与对照和空载组相比,不同剂量pEGF-NZ上清处理组D450 nm值均显著升高(P<0.05,图15)。
pEGF蛋白在小鼠体内生物活性鉴定
1.腹泻率及日增重

CON组小鼠被毛光滑、浓密,无腹泻;鼠伤寒沙门菌CVCC542感染后,腹泻模型组小鼠被毛紊乱,精神慵懒,喜爱扎堆;与模型组相比,pEGF-NZ菌液预防、pEGF-NZ上清预防、pEGF-NZ菌液治疗、pEGF-NZ上清治疗组小鼠被毛较密且光滑,腹泻率较低。由表2可知,各组小鼠初始体重、终末体重、1~10 d各组平均日增重均无显著差异(P>0.05)。与空白组相比,12~21 d腹泻模型、pEGF-NZ菌液预防组小鼠日增重均显著升高(P<0.05)。
2.肠道组织形态观察

组织切片观察结果显示,空白组小鼠小肠绒毛较密,肠黏膜形态完整。腹泻模型、V-NZ菌液预防、V-NZ菌液治疗组小鼠的十二指肠、空肠、回肠肠绒毛坏死、脱落严重;与腹泻模型组相比,pEGF-NZ菌液预防、pEGF-NZ上清预防、pEGF-NZ菌液治疗、pEGF-NZ上清治疗组肠绒毛高度较高,肠绒毛较密,且pEGF-NZ菌液治疗、pEGF-NZ上清治疗组肠黏膜形态较完整(图16)。
3.结肠菌群

由表3可知,与模型和V-NZ菌液治疗组相比,pEGF-NZ菌液治疗、pEGF-NZ上清治疗组结肠中大肠杆菌数、肠球菌数均显著降低(P<0.05);pEGF-NZ上清治疗组双歧杆菌数显著高于空白组(P<0.05);pEGF-NZ上清预防、pEGF-NZ菌液治疗、pEGF-NZ上清治疗组乳酸菌数显著高于腹泻模型和空白组(P<0.05)。
4.血清细胞因子

由表4可知,与腹泻模型组相比,pEGF-NZ菌液预防组小鼠血清中IL-1α、IL-1β、GM-CSF含量均显著降低(P<0.05),CXCL1、IL-13含量均显著升高(P<0.05);pEGF-NZ上清预防组小鼠血清中IL-1α含量显著降低,CXCL1含量显著升高(P<0.05);pEGF-NZ菌液治疗组小鼠血清中IL-1α、GM-CSF含量均显著降低,CXCL1、IL-1β、IL-13、MCP-1、TNF-α、IL-17含量均显著升高(P<0.05);pEGF-NZ上清治疗组小鼠血清中CCL5含量显著降低,CXCL1、IL-13、TNF-α含量显著升高(P<0.05)。
pEGF蛋白在断奶仔猪体内生物活性鉴定

由表5可知,与空白对照组相比,pEGF-NZ组断奶仔猪平均日增重有增长趋势,但差异不显著(P>0.05)。

本研究成功构建了表达pEGF的无抗乳酸乳球菌原核表达系统,并验证了其在体外和体内的生物活性。结果表明:重组pEGF具有良好生物活性,能够促进肠上皮细胞增殖及肠绒毛发育,修复受损肠上皮,抑制病原菌的黏附,调控肠道菌群、降低腹泻率、抑制炎症的发生。这些发现为研发保护断奶仔猪肠道健康制剂提供了技术支撑。



